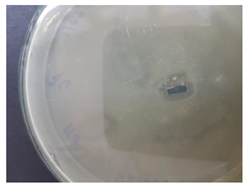
Coatings 10 00642 i001 Coatings 10 00642 i001

CeO2 Containing Thin Films as Bioactive Coatings for Orthopaedic Implants
Abstract
1. Introduction
2. Materials and Methods
2.1. Materials
2.2. Synthesis of the Precursor Powder
2.3. Fabrication of the Final Target
2.4. Deposition of the Thin Films
2.5. Characterisation Techniques
2.6. Bioactivity Assessment
2.7. Antibacterial Activity Evaluation
2.8. Biocompatibility Evaluation
3. Results and Discussion
3.1. SEM Analysis
3.2. EDX analysis
3.3. FTIR Analysis
3.4. XRD Analysis
3.5. Biological Analysis
4. Conclusions
Author Contributions
Funding
Acknowledgments
Conflicts of Interest
References
- Dawson, D.R.; El-Ghannam, A.; Van Sickels, J.E.; Naung, N.Y. Tissue engineering: What is new? Dent. Clin. N. Am. 2019, 63, 433–445. [Google Scholar] [CrossRef]
- Sabudin, S.; Marzuke, M.A.; Hussin, Z. Effect of mechanical properties on porous calcium phosphate scaffold. Mater. Today Proc. 2019, 16, 1680–1685. [Google Scholar] [CrossRef]
- Zhao, C.Q.; Xu, X.C.; Lu, Y.J.; Wu, S.Q.; Xu, Z.Y.; Huang, T.T.; Lin, J.X. Doping lithium element to enhance compressive strength of β-TCP scaffolds manufactured by 3D printing for bone tissue engineering. J. Alloys Compd. 2020, 814, 152327. [Google Scholar] [CrossRef]
- El-Fiqi, A.; Kim, J.H.; Kim, H.W. Novel bone-mimetic nanohydroxyapatite collagen porous scaffolds biomimetically mineralized from surface silanized mesoporous nanobioglass/collagen hybrid scaffold: Physicochemical, mechanical and in vivo evaluations. Mater. Sci. Eng. C 2020, 110, 110660. [Google Scholar] [CrossRef] [PubMed]
- Singh, B.N.; Veeresh, V.; Mallick, S.P.; Sinha, S.; Rastogi, A.; Srivastava, P. Generation of scaffold incorporated with nanobioglass encapsulated in chitosan/chrondoitin suflate complex for bone tissue engineering. Int. J. Biol. Macromol. 2020, 153, 1–16. [Google Scholar] [CrossRef] [PubMed]
- Shaltooki, M.; Dini, G.; Mehdikhani, M. Fabrication of chitosan coated porous polycaprolactone strontium substituted bioactive glass nanocomposite scaffold for bone tissue engineering. Mater. Sci. Eng. C 2019, 105, 110138. [Google Scholar] [CrossRef] [PubMed]
- Wang, L.; Yang, P. Nanostructured scaffold and its bioactive potentials in bone tissue engineering. In Nanobiomaterials in Hard Tissue Engineering: Applications of Nanobiomaterials; Grumezescu, A.M., Ed.; Elsevier: Amsterdam, The Netherlands, 2016; Volume 4, pp. 241–270. [Google Scholar]
- Rahaman, M.N.; Day, D.E.; Bal, B.S.; Fu, Q.; Jung, S.B.; Bonewald, L.F.; Tomsia, A.P. Bioactive glass in tissue engineering. Acta Biomater. 2011, 7, 2355–2373. [Google Scholar] [CrossRef] [PubMed]
- Gerhardt, L.C.; Boccaccini, A.R. Bioactive glass and glass-ceramic scaffolds for bone tissue engineering. Materials 2010, 3, 3867–3910. [Google Scholar] [CrossRef]
- Shuai, C.; Xu, Y.; Feng, P.; Wang, G.; Xiong, S.; Peng, S. Antibacterial polymer scaffold based on mesoporous bioactive glass loaded with in situ grown silver. Chem. Eng. J. 2019, 374, 304–315. [Google Scholar] [CrossRef]
- Oliver, J.N.; Su, Y.; Lu, X.; Kuo, P.H.; Du, J.; Zhu, D. Bioactive glass coatings on metallic implants for biomedical applications. Bioact. Mater. 2019, 4, 261–270. [Google Scholar] [CrossRef]
- Nabiyouni, M.; Bruckner, T.; Zhou, H.; Gbureck, U.; Bhaduri, S.B. Magnesium-based bioceramics in orthopedic applications. Acta Biomater. 2018, 66, 23–43. [Google Scholar] [CrossRef] [PubMed]
- Kargozar, S.; Montazerian, M.; Fiume, E.; Baino, F. Multiple and promising applications of strontium (Sr)-containing bioactive glasses in bone tissue engineering. Front. Bioeng. Biotechnol. 2019, 7, 161. [Google Scholar] [CrossRef] [PubMed]
- Miola, M.; Brovarone, C.V.; Maina, G.; Rossi, F.; Bergandi, L.; Ghigo, D.; Saracino, S.; Maggiora, M.; Canuto, R.A.; Muzio, M.; et al. In vitro study of manganese-doped bioactive glasses for bone regeneration. Mater. Sci. Eng. C 2014, 38, 107–118. [Google Scholar] [CrossRef] [PubMed]
- Singh, R.K.; Srinivasan, A. Bioactivity of SiO2–CaO–P2O5–Na2O glasses containing zinc-iron oxide. Appl. Surf. Sci. 2010, 256, 1725–1730. [Google Scholar] [CrossRef]
- Aina, V.; Perardi, A.; Bergandi, L.; Malavasi, G.; Menabue, L.; Morterra, C.; Ghigo, D. Cytotoxicity of zinc-containing bioactive glasses in contact with human osteoblasts. Chem. Biol. Interact. 2007, 167, 207–218. [Google Scholar] [CrossRef]
- Mirzaee, M.; Vaezi, M.; Palizdar, Y. Synthesis and characterization of silver doped hydroxyapatite nanocomposite coatings and evaluation of their antibacterial and corrosion resistance properties in simulated body fluid. Mater. Sci. Eng. C 2016, 69, 675–684. [Google Scholar] [CrossRef]
- Leonelli, C.; Lusvardi, G.; Malavasi, G.; Menabue, L.; Tonelli, M. Synthesis and characterization of cerium-doped glasses and in vitro evaluation of bioactivity. J. Non-Cryst. Solids 2003, 316, 198–216. [Google Scholar] [CrossRef]
- Atkinson, I.; Anghel, E.M.; Petrescu, S.; Seciu, A.M.; Stefan, L.M.; Mocioiu, O.C.; Predoana, L.; Voicescu, M.; Somacescu, S.; Culita, D.; et al. Cerium-containing mesoporous bioactive glasses: Material characterization, in vitro bioactivity, biocompatibility and cytotoxicity evaluation. Microporous Mesoporous Mater. 2019, 276, 76–88. [Google Scholar] [CrossRef]
- Farias, I.A.P.; dos Santos, C.C.L.; Sampaio, F.C. Antimicrobial activity of cerium oxide nanoparticles on opportunistic microorganisms: A systematic review. BioMed Res. Int. 2018, 2018, 1923606. [Google Scholar] [CrossRef]
- Gopinath, K.; Karthika, V.; Sundaravadivelan, C.; Gowri, S.; Arumugam, A. Mycogenesis of cerium oxide nanoparticles using Aspergillus niger culture filtrate and their applications for antibacterial and larvicidal activities. J. Nanostructure Chem. 2015, 5, 295–303. [Google Scholar] [CrossRef]
- Masadeh, M.M.; Karasneh, G.A.; Al-Akhras, M.A.; Albiss, B.A.; Aljarah, K.M.; Al-Azzam, S.I.; Alzoubi, K.H. Cerium oxide and iron oxide nanoparticles abolish the antibacterial activity of ciprofloxacin against gram positive and gram negative biofilm bacteria. Cytotechnology 2015, 67, 427–435. [Google Scholar] [CrossRef] [PubMed]
- Li, R.; Clark, A.E.; Hench, L.L. An investigation of bioactive glass powders by sol-gel processing. J. Appl. Biomater. 1991, 2, 231–239. [Google Scholar] [CrossRef] [PubMed]
- Kaur, G.; Pickrell, G.; Sriranganathan, N.; Kumar, V.; Homa, D. Review and the state of the art: Sol-gel and melt quenched bioactive glasses for tissue engineering. J. Biomed. Mater. Res. B 2016, 104, 1248–1275. [Google Scholar] [CrossRef] [PubMed]
- Aina, V.; Bonino, F.; Morterra, C.; Miola, M.; Bianchi, C.L.; Malavasi, G.; Marchetti, M.; Bolis, V. Influence of the chemical composition on nature and activity of the surface layer of Zn-substituted sol-gel (bioactive) glasses. J. Phys. Chem. C 2011, 115, 2196–2210. [Google Scholar] [CrossRef]
- Kargozar, S.; Kermani, F.; Mollazadeh Beidokhti, S.; Hamzehlou, S.; Verne, E.; Ferraris, S.; Baino, F. Functionalization and surface modifications of bioactive glasses (BGs): Tailoring of the biological response working on the outermost surface layer. Materials 2019, 12, E3696. [Google Scholar] [CrossRef]
- Sepulveda, P.; Jones, J.R.; Hench, L.L. Characterization of melt-derived 45S5 and sol-gel-derived 58S bioactive glasses. J. Biomed. Mater. Res. 2001, 58, 734–740. [Google Scholar] [CrossRef]
- Krebs, H.U.; Weisheit, M.; Faupel, J.; Suske, E.; Scharf, T.; Fuhse, C.; Stormer, M.; Sturm, K.; Seibt, M.; Kijewski, H.; et al. Pulsed laser deposition (PLD)-A versatile thin film technique. In Advances in Solid State Physics; Kramer, B., Ed.; Springer: Berlin, Germany, 2003; Volume 43, pp. 505–518. [Google Scholar]
- Tanaskovic, D.; Jokic, B.; Socol, G.; Popescu, A.; Mihailescu, I.N.; Petrovic, R.; Janackovic, D. Synthesis of functionally graded bioactive glass-apatite multistructures on Ti substrates by pulsed laser deposition. Appl. Suf. Sci. 2007, 254, 1279–1282. [Google Scholar] [CrossRef]
- Jinga, S.I.; Skokin, M.; Vasile, B.S.; Constantinoiu, I.; Miu, D.; Bacalum, M.; Busuioc, C. Development of vitroceramic coatings and analysis of their suitability for biomedical applications. Coatings 2019, 9, 671. [Google Scholar] [CrossRef]
- Negrea, R.; Busuioc, C.; Constantinoiu, I.; Miu, D.; Enache, C.; Iordache, F.; Jinga, S.I. Akermanite based coatings grown by pulsed laser deposition for metallic implants employed in orthopaedics. Surf. Coat. Technol. 2019, 357, 1015–1026. [Google Scholar] [CrossRef]
- Jonauske, V.; Stanionyte, S.; Chen, S.W.; Zarkov, A.; Juskenas, R.; Selskis, A.; Matijosius, T.; Yang, T.C.K.; Ishikawa, K.; Ramanauskas, R.; et al. Characterization of sol-gel derived calcium hydroxyapatite coatings fabricated on patterned rough stainless steel surface. Coatings 2019, 9, 334. [Google Scholar] [CrossRef]
- Voicu, G.; Miu, D.; Ghitulica, C.D.; Jinga, S.I.; Nicoara, A.I.; Busuioc, C.; Holban, A.M. Co doped ZnO thin films deposited by spin coating as antibacterial coating for metallic implants. Ceram. Int. 2020, 46, 3904–3911. [Google Scholar] [CrossRef]
- Busuioc, C.; Constantinoiu, I.; Enculescu, M.; Beregoi, M.; Jinga, S.I. Ceramic thin films deposited by spin coating as coatings for metallic implants. Romanian J. Mater. 2018, 48, 401–406. [Google Scholar]
- Brunello, G.; Elsayed, H.; Biasetto, L. Bioactive glass and silicate-based ceramic coatings on metallic implants: Open challenge or outdated topic? Materials 2019, 12, 2929. [Google Scholar] [CrossRef] [PubMed]
- Berbecaru, C.; Alexandru, H.V.; Ianculescu, A.; Popescu, A.; Socol, G.; Sima, F.; Mihailescu, I. Bioglass thin films for biomimetic implants. Appl. Surf. Sci. 2009, 255, 5476–5479. [Google Scholar] [CrossRef]
- Gyorgy, E.; Grigorescu, S.; Socol, G.; Mihailescu, I.N.; Janackovic, D.; Dindune, A.; Kanepe, Z.; Palcevskis, E.; Zdrentu, E.L.; Petrescu, S.M. Bioactive glass and hydroxyapatite thin films obtained by pulsed laser deposition. Appl. Surf. Sci. 2007, 253, 7981–7986. [Google Scholar] [CrossRef]
- Lowndes, D.H.; Geohegan, D.B.; Puretzky, A.A.; Norton, D.P.; Rouleau, C.M. Synthesis of novel thin-film materials by pulsed laser deposition. Science 1996, 273, 898–903. [Google Scholar] [CrossRef]
- Deliormanli, A.M. Electrospun cerium and gallium-containing silicate based 13-93 bioactive glass fibers for biomedical applications. Ceram. Int. 2016, 42, 897–906. [Google Scholar] [CrossRef]
- Nicolini, V.; Malavasi, G.; Menabue, L.; Lusvardi, G.; Benedetti, F.; Valeri, S.; Luches, P. Cerium-doped bioactive 45S5 glasses: spectroscopic, redox, bioactivity and biocatalytic properties Valentina. J. Mater. Sci. 2017, 52, 8845–8857. [Google Scholar] [CrossRef]
- Morais, D.S.; Fernandes, S.; Gomes, P.S.; Fernandes, M.H.; Sampaio, P.; Farraz, M.P.; Santos, J.D.; Lopes, M.A.; Hussain, N.S. Novel cerium doped glass-reinforced hydroxyapatite with antibacterial and osteoconductive properties for bone tissue regeneration. Biomed. Mater. 2015, 10, 055008. [Google Scholar] [CrossRef]
- Goh, Y.F.; Alshemary, A.Z.; Akram, M.; Kadir, M.R.A.; Hussain, R. In-vitro characterization of antibacterial bioactive glass containing ceria. Ceram. Int. 2014, 40, 729–737. [Google Scholar] [CrossRef]
- Borges, R.; Schneider, J.F.; Marchi, J. Structural characterization of bioactive glasses containing rare earth elements (Gd and/or Yb). J. Mater. Sci. 2019, 54, 11390–11399. [Google Scholar] [CrossRef]
- Moghanian, A.; Firoozi, S.; Tahriri, M.; Sedghi, A. A comparative study on the in vitro formation of hydroxyapatite, cytotoxicity and antibacterial activity of 58S bioactive glass substituted by Li and Sr. Mater. Sci. Eng. C 2018, 91, 349–360. [Google Scholar] [CrossRef] [PubMed]
- Krishnamacharyulu, N.; Mohini, G.J.; Baskaran, G.S.; Kumar, V.R.; Veeraiah, N. Investigation on silver doped B2O3–SiO2–P2O5–Na2O–CaO bioglass system for biomedical applications. J. Alloys Compd. 2018, 734, 318–328. [Google Scholar] [CrossRef]
- Shahrbabak, M.S.N.; Sharifianjazi, F.; Rahban, D.; Salimi, A. A comparative investigation on bioactivity and antibacterial properties of sol-gel derived 58S bioactive glass substituted by Ag and Zn. Silicon 2019, 11, 2741–2751. [Google Scholar] [CrossRef]
- Baino, F.; Hamzehlou, S.; Kargozar, S. Bioactive glasses: Where are we and where are we going? J. Funct. Biomater. 2018, 9, 25. [Google Scholar] [CrossRef]
- Kokubo, T.; Takadama, H. How useful is SBF in predicting in vivo bone bioactivity? Biomater. 2006, 27, 2907–2915. [Google Scholar] [CrossRef]
- Puvaneswary, S.; Raghavendran, H.B.; Talebian, S.; Murali, M.R.; Mahmod, S.A.; Singh, S.; Kamarul, T. Incorporation of Fucoidan in β-Tricalcium phosphate-Chitosan scaffold prompts the differentiation of human bone marrow stromal cells into osteogenic lineage. Sci. Rep. 2016, 6, 24202. [Google Scholar] [CrossRef]
- Mehdipour, M.; Afshar, A.; Mohebali, M. Electrophoretic deposition of bioactive glass coating on 316L stainless steel and electrochemical behavior study. Appl. Surf. Sci. 2012, 258, 9832–9839. [Google Scholar] [CrossRef]
- Choudhary, R.; Koppala, S.; Swamiappan, S. Bioactivity studies of calcium magnesium silicate prepared from eggshell waste by sol-gel combustion synthesis. J. Asian Ceram. Soc. 2015, 3, 173–177. [Google Scholar] [CrossRef]
- Zamiri, R.; Ahangar, H.A.; Kaushal, A.; Zakaria, A.; Zamiri, G.; Tobaldi, D.; Ferreira, J.M.F. Dielectrical properties of CeO2 nanoparticles at different temperatures. PLoS ONE 2015, 10, e0122989. [Google Scholar]
- Cabanas-Tay, S.A.; Palacios-Huerta, L.; Aceves-Mijares, M.; Coyopol, A.; Perez-Garcia, S.A.; Licea-Jimenez, L.; Dominguez, C.; Morales-Sanchez, A. Luminescent devices based on silicon-rich dielectric materials. In Luminescence—An Outlook on the Phenomena and their Applications; Thirumalai, J., Ed.; IntechOpen: London, UK, 2016; pp. 159–187. [Google Scholar]
- Fazio, E.; Barletta, E.; Barreca, F.; Neri, F.; Trusso, S. Investigation of a nanocrystalline silicon phase embedded in SiOx thin films grown by pulsed laser deposition. J. Vac. Sci. Technol. B 2005, 23, 519–524. [Google Scholar] [CrossRef]
- Roebben, G.; Kestens, V.; Varga, Z.; Charoud-Got, J.; Ramaye, Y.; Gollwitzer, C.; Bartczak, D.; Geissler, D.; Noble, J.; Mazoua, S.; et al. Reference materials and representative test materials to develop nanoparticle characterization methods: The NanoChOp project case. Front. Chem. 2015, 3, 56. [Google Scholar] [CrossRef] [PubMed]
- Chellappa, M.; Anjaneyulu, U.; Manivasagam, G.; Vijayalakshmi, U. Preparation and evaluation of the cytotoxic nature of TiO2 nanoparticles by direct contact method. Int. J. Nanomed. 2015, 10, 31–41. [Google Scholar]
- Lee, H.B.; Hsu, H.C.; Wu, S.C.; Hsu, S.K.; Wang, P.H.; Ho, W.F. Microstructure and characteristics of calcium phosphate layers on bioactive oxide surfaces of air-sintered titanium foams after immersion in simulated body fluid. Materials 2016, 9, 956. [Google Scholar] [CrossRef] [PubMed]
- Ponnurangam, S.; O’Connell, G.D.; Chernyshova, I.V.; Wood, K.; Hung, C.T.H.; Somasundaran, P. Beneficial effects of cerium oxide nanoparticles in development of chondrocyte-seeded hydrogel constructs and cellular response to interleukin insults. Tissue Eng. A 2014, 20, 2908–2919. [Google Scholar] [CrossRef]
- Kannan, S.K.; Sundrarajan, M. A green approach for the synthesis of a cerium oxide nanoparticle: Characterization and antibacterial activity. Int. J. Nanosci. 2014, 13, 1450018. [Google Scholar] [CrossRef]
- Reshma, P.; Ashwini, K. Cerium oxide nanoparticles: Synthesis, characterization and study of antimicrobial activity. J. Nanomater. Mol. Nanotechnol. 2017, 6, 3. [Google Scholar] [CrossRef]
- Karakoti, A.S.; Tsigkou, O.; Yue, S.; Lee, P.D.; Stevens, M.M.; Jones, J.R.; Seal, S. Rare earth oxides as nanoadditives in 3-D nanocomposite scaffolds for bone regeneration. J. Mater.Chem. 2010, 20, 8912–8919. [Google Scholar] [CrossRef]
- Ghomi, H.; Emadi, R.; Javanmard, S.H. Preparation of nanostructure bioactive diopside scaffolds for bone tissue engineering by two near net shape manufacturing techniques. Mater. Lett. 2016, 167, 157–160. [Google Scholar] [CrossRef]
- Anesi, A.; Malavasi, G.; Chiarini, L.; Salvatori, R.; Lusvardi, G. Cell proliferation to evaluate preliminarily the presence of enduring self-regenerative antioxidant activity in cerium doped bioactive glasses. Materials 2020, 13, 2297. [Google Scholar] [CrossRef]
- Zheng, K.; Torre, E.; Bari, A.; Taccardi, N.; Cassinelli, C.; Morra, M.; Fiorilli, S.; Vitale-Brovarone, C.; Iviglia, G.; Boccaccini, A.R. Antioxidant mesoporous Ce-doped bioactive glass nanoparticles with anti-inflammatory and pro-osteogenic activities. Mater. Today Bio 2020, 5, 100041. [Google Scholar] [CrossRef] [PubMed]
- Lusvardi, G.; Sgarbi Stabellini, F.; Salvatori, R. P2O5-free cerium containing glasses: Bioactivity and cytocompatibility evaluation. Materials 2019, 12, 3267. [Google Scholar] [CrossRef] [PubMed]
- Malavasi, G.; Salvatori, R.; Zambon, A.; Lusvardi, G.; Rigamonti, L.; Chiarini, L.; Anesi, A. Cytocompatibility of potential bioactive cerium-doped glasses based on 45S5. Materials 2019, 12, 594. [Google Scholar] [CrossRef] [PubMed]
- Lapa, A.; Cresswell, M.; Campbell, I.; Jackson, P.; Goldmann, W.H.; Detsch, R.; Parsons, A.; Ahmede, I.; Boccaccini, A.R. Ga and Ce ion-doped phosphate glass fibres with antibacterial properties and their composite for wound healing applications. J. Mater. Chem. B 2019, 7, 6981–6993. [Google Scholar] [CrossRef] [PubMed]
- Nicolini, V.; Varini, E.; Malavasi, G.; Menabue, L.; Menziani, M.C.; Lusvardi, G.; Pedone, A.; Benedetti, F.; Luches, P. The effect of composition on structural, thermal, redox and bioactive properties of Ce-containing glasses. Mater. Des. 2016, 97, 73–85. [Google Scholar] [CrossRef]
- Naganuma, T.; Traversa, E. The effect of cerium valence states at cerium oxide nanoparticle surfaces on cell proliferation. Biomaterials 2014, 35, 4441–4453. [Google Scholar] [CrossRef]
- Celardo, I.; Pedersen, J.Z.; Traversa, E.; Ghibelli, L. Pharmacological potential of cerium oxide nanoparticles. Nanoscale 2011, 3, 1411–1420. [Google Scholar] [CrossRef]
- Hoppe, A.; Guldal, N.S.; Boccaccini, A.R. A review of the biological response to ionic dissolution products from bioactive glasses and glass-ceramics. Biomaterials 2011, 32, 2757–2774. [Google Scholar] [CrossRef]








| Oxide | SiO2 | P2O5 | CaO | MgO | Na2O | CeO2 |
|---|---|---|---|---|---|---|
| Oxide concentration (mol%) | 46.10 | 2.60 | 16.90 | 10.00 | 19.40 | 5.00 |
| Reagent | Si(OC2H5)4 | (C2H5O)3PO | Ca(NO3)2·4H2O | Mg(NO3)2·6H2O | NaNO2 | (NH4)2Ce(NO3)6 |
| Sample Code | Deposition Method | Substrate Type | Processing Temperature (°C) | Other Parameters |
|---|---|---|---|---|
| PLD-RT | Pulsed laser deposition | Silicon plate | Room temperature | • 355 nm wavelength • 73–74 mJ/pulse energy • 15,000 pulses • 40 mm distance target—substrate • 100 mTorr oxygen pressure |
| PLD-300 | 300 | |||
| SC-Ti | Spin coating | Titanium plate | 650 | • 2000 rpm/s acceleration • 8000 rpm rotation speed • 60 s rotation time • clockwise direction |
| SC-Al2O3 | Alumina plate |
| Sample | Before SBF Immersion | After SBF Immersion | ||||
|---|---|---|---|---|---|---|
| Ca (wt.%) | P (wt.%) | Ca/P | Ca (wt.%) | P (wt.%) | Ca/P | |
| PLD-RT | 15.64 | 3.07 | 5.09 | 30.67 | 42.30 | 0.73 |
| PLD-300 | 15.04 | 2.71 | 5.55 | 27.63 | 43.79 | 0.63 |
| SC-Ti | 15.44 | 3.79 | 4.07 | 6.25 | 4.04 | 1.55 |
| Sample | Area of Sample (mm2) | Inhibition Zone (mm2) | Antibacterial Activity Evaluation |
|---|---|---|---|
| PLD-RT | 12.00 | 72.82![]() | High |
| PLD-300 | 11.25 | 43.73![]() | Moderate |
| SC-Al2O3 | 11.50 | 41.12![]() | Moderate |
| Target | 9.00 | 13.11![]() | Poor |
© 2020 by the authors. Licensee MDPI, Basel, Switzerland. This article is an open access article distributed under the terms and conditions of the Creative Commons Attribution (CC BY) license (http://creativecommons.org/licenses/by/4.0/).
Share and Cite
Prefac, G.-A.; Milea, M.-L.; Vadureanu, A.-M.; Muraru, S.; Dobrin, D.-I.; Isopencu, G.-O.; Jinga, S.-I.; Raileanu, M.; Bacalum, M.; Busuioc, C. CeO2 Containing Thin Films as Bioactive Coatings for Orthopaedic Implants. Coatings 2020, 10, 642. https://doi.org/10.3390/coatings10070642
Prefac G-A, Milea M-L, Vadureanu A-M, Muraru S, Dobrin D-I, Isopencu G-O, Jinga S-I, Raileanu M, Bacalum M, Busuioc C. CeO2 Containing Thin Films as Bioactive Coatings for Orthopaedic Implants. Coatings. 2020; 10(7):642. https://doi.org/10.3390/coatings10070642
Chicago/Turabian StylePrefac, Georgiana-Alexandra, Marina-Larisa Milea, Andreea-Mihaela Vadureanu, Sorin Muraru, Daniela-Ileana Dobrin, Gabriela-Olimpia Isopencu, Sorin-Ion Jinga, Mina Raileanu, Mihaela Bacalum, and Cristina Busuioc. 2020. "CeO2 Containing Thin Films as Bioactive Coatings for Orthopaedic Implants" Coatings 10, no. 7: 642. https://doi.org/10.3390/coatings10070642
APA StylePrefac, G.-A., Milea, M.-L., Vadureanu, A.-M., Muraru, S., Dobrin, D.-I., Isopencu, G.-O., Jinga, S.-I., Raileanu, M., Bacalum, M., & Busuioc, C. (2020). CeO2 Containing Thin Films as Bioactive Coatings for Orthopaedic Implants. Coatings, 10(7), 642. https://doi.org/10.3390/coatings10070642